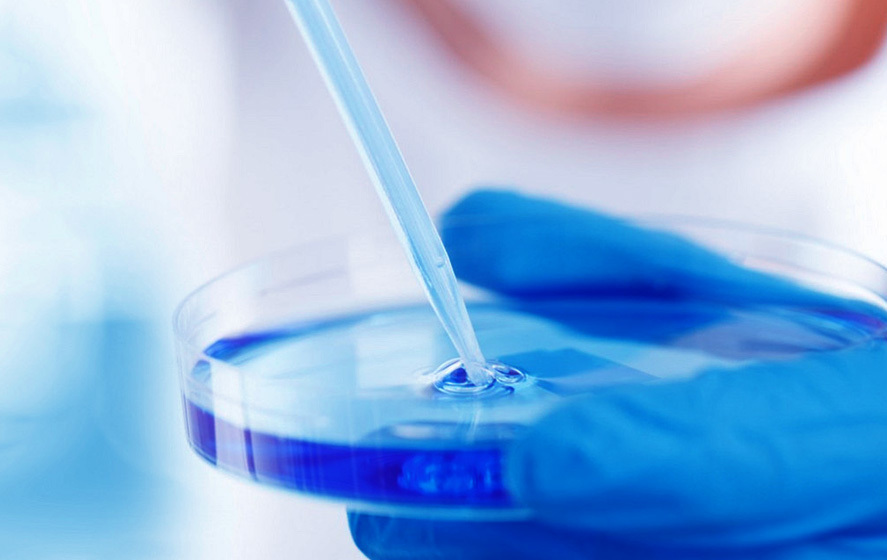

走进我们
ABOUT US
黄石法姆药业股份有限公司是国家高新技术企业,湖北省专精特新企业。是生产痛风药别嘌醇及抗菌药硝呋齐特产品的全球规模企业。 其中别嘌醇是国内规模最大生产企业。公司的别嘌醇产品销往印尼、以色列、俄罗斯、泰国、印尼、黎巴嫩、加拿大、哥伦比亚等国。 公司前身为南京法姆化学厂, 2013年,公司法人隋宁先生应黄石市西塞山区招商局邀请,于当年11月6日成立黄石法姆药业股份有限公司。公司位于黄石市西塞山区黄石生物医药产业园区内,占地面积30亩,建有2个GMP标准合成车间、医药中间体生产线和理化质量检测中心,生产技术先进,检测设备完善。主要从事医药原料及中间体,农药中间体及精细有机化学品的开发和生产。其产品质量可靠,产品100%销往国际市场。现年产500吨别嘌醇、 200吨硝吠酚酰肼(别名硝呋齐特)及 300 吨其他医药中间体。 公司团队现有人员60人,其中高级工程师5人,高级技术专家顾问2人,高级技师12人,技术人员占公司总人数的55% ,研发人员占公司总人数的16 % ,拥有企业工程技术研发中心专门从事新产品研发、工艺改进和质量研究工作。同时与南京大学化学化工学院、中国药科大学、湖北理工学院等大量院校科研机构建有广泛的合作关系。 几年来,公司领导通过敏锐的市场观察力,结合自身的企业发展具体情况,制定了以别嘌醇为主,多种小产品为辅共同发展的战略发展规划。公司生产的产品符合 EP/BP...
公司成立2013年
占地20000余平米
年生产能力可达1000吨
产品中心
黄石法姆药业股份有限公司主要从事医药原料及中间体,农药中间体及精细有机化学品的开发和生产。其产品质量可靠,产品100%销往国际市场。现年产500吨别嘌醇、 200吨硝吠酚酰肼(别名硝呋齐特)及 300 吨其他医药中间体。
全部产品 >>
负责人:18827685429
销售热线:13995963747
售后电话:13995963747
企业邮箱:njpc@163.com;xiebihuan@163.com
公司地址:湖北省黄石市西塞山工业园三园路6号
工信部ICP备案
编号:鄂ICP备2022010774号-3
黄石法姆药业股份有限公司 | 主要从事别嘌醇及硝吠酚酰肼等原料药中间体生产

18827685429
18827685429 

 njpc@163.com;xiebihuan@163.com
njpc@163.com;xiebihuan@163.com 